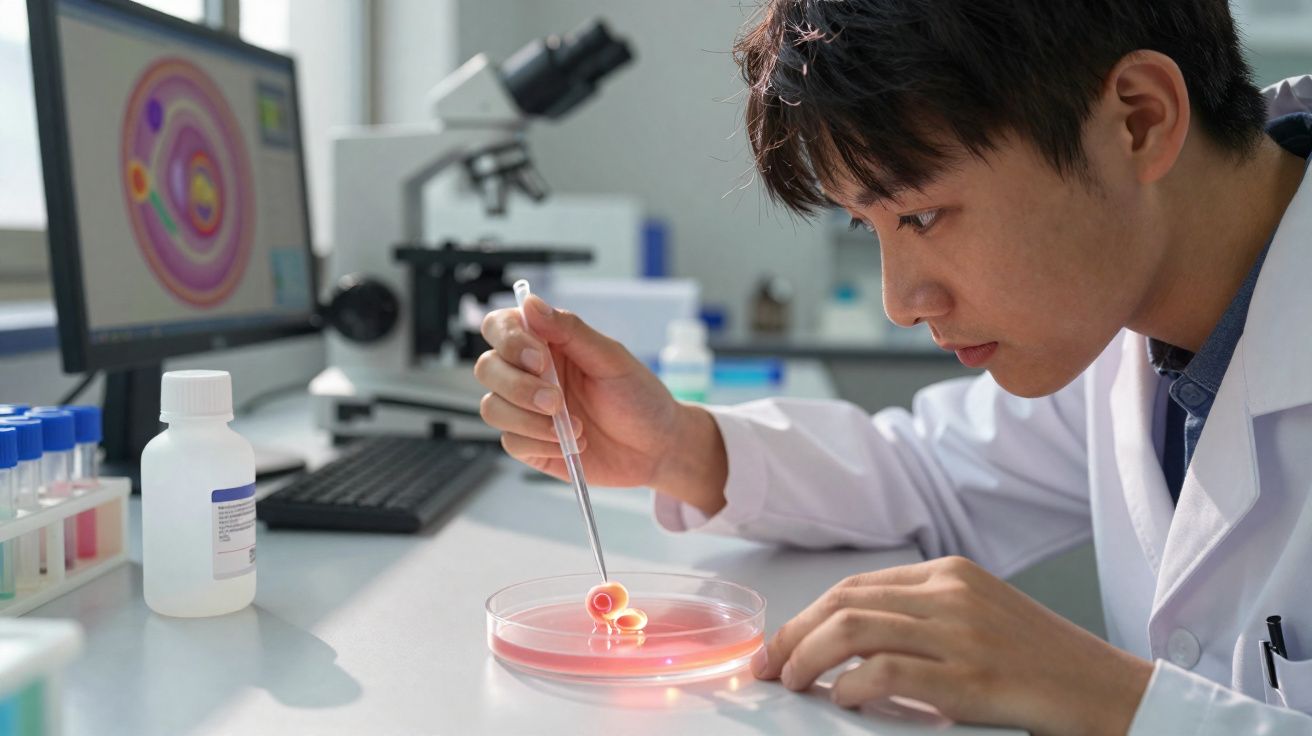
Jeune scientifique en blouse blanche manipulant une pipette au-dessus d'une boîte de Pétri en laboratoire.

La plupart des gens savent qu’ils devraient boire davantage d’eau. Nos nouveaux travaux mettent pourtant en lumière une conséquence inattendue d’un apport insuffisant : cela pourrait rendre le stress du quotidien nettement plus difficile à gérer.
Notre étude, publiée dans le Journal de physiologie appliquée, montre que les personnes qui boivent moins de 1,5 litre par jour présentent des niveaux de cortisol - la principale hormone du stress - beaucoup plus élevés lorsqu’elles sont confrontées à des situations stressantes.
Ce résultat suggère qu’une déshydratation légère mais chronique pourrait intensifier la réponse au stress, d’une manière que nous commençons à peine à comprendre.
Pour tester cette hypothèse, nous avons recruté de jeunes adultes en bonne santé et nous les avons répartis en deux groupes selon leur consommation habituelle de liquides. Le premier buvait moins de 1,5 litre par jour ; le second dépassait les recommandations courantes, à savoir environ deux litres pour les femmes et 2,5 litres pour les hommes.
Après une semaine passée à maintenir ces habitudes, les participants ont été soumis à un test de stress en laboratoire combinant prise de parole en public et calcul mental.
Dans les deux groupes, les participants se sont dits tout aussi nerveux et ont montré des augmentations comparables de la fréquence cardiaque. En revanche, le groupe à faible apport hydrique a présenté une hausse de cortisol bien plus marquée - une réaction qui pourrait devenir problématique si elle se répétait jour après jour pendant des mois ou des années. Une élévation chronique du cortisol a été associée à un risque accru de maladies cardiaques, d’atteintes rénales et de diabète.
Fait surprenant, les participants insuffisamment hydratés n’ont pas déclaré ressentir davantage la soif que ceux correctement hydratés. Leurs organismes racontaient toutefois une autre histoire : une urine plus foncée et plus concentrée révélait la déshydratation, ce qui illustre que la soif n’est pas toujours un indicateur fiable des besoins en eau.
Le mécanisme susceptible d’expliquer cette amplification de la réponse au stress repose sur le système sophistiqué de régulation de l’eau dans le corps. Lorsqu’une déshydratation est détectée, le cerveau libère de la vasopressine, une hormone qui demande aux reins d’économiser l’eau et de préserver le volume sanguin.
Mais la vasopressine n’agit pas seule : elle influence également le système cérébral de réponse au stress, ce qui peut favoriser une libération plus importante de cortisol lors des moments difficiles.
Double peine : hydratation, vasopressine et cortisol face au stress
Cela crée une double charge physiologique. D’un côté, la vasopressine contribue à sauvegarder une ressource précieuse - l’eau. De l’autre, elle peut rendre l’organisme plus réactif au stress. Pour une personne confrontée aux pressions de tous les jours - échéances professionnelles, responsabilités familiales, inquiétudes financières - cette réactivité accrue peut, à la longue, s’accumuler et entraîner des dommages importants sur la santé.
Nos résultats ajoutent l’hydratation à la liste grandissante des facteurs de mode de vie qui influencent la résistance au stress. Le sommeil, l’activité physique, l’alimentation et les liens sociaux jouent tous un rôle dans la manière dont nous faisons face aux défis de la vie. L’eau apparaît désormais comme une alliée potentiellement sous-estimée dans la gestion du stress.
Les implications dépassent la seule physiologie individuelle. Dans des sociétés où le stress chronique est de plus en plus reconnu comme une crise de santé publique, l’hydratation ressort comme une mesure étonnamment accessible. Contrairement à de nombreuses stratégies de gestion du stress qui exigent du temps ou des ressources, boire suffisamment d’eau est simple et à la portée de tous.
Pour autant, notre recherche ne laisse pas entendre que l’eau serait une solution universelle au stress. L’étude a été menée chez de jeunes adultes en bonne santé, dans des conditions de laboratoire contrôlées, qui ne peuvent pas reproduire pleinement la complexité des facteurs psychologiques et sociaux auxquels les personnes sont confrontées au quotidien.
L’hydratation, à elle seule, ne peut pas traiter toutes les dimensions du stress dans la vie réelle. Des études au long cours sont nécessaires pour vérifier si le maintien d’une hydratation optimale réduit réellement les problèmes de santé liés au stress sur des années, voire des décennies.
Les besoins en eau varient fortement selon l’âge, la corpulence, le niveau d’activité et le climat. Les recommandations fournissent des repères utiles, mais le thé, le café, le lait et les aliments riches en eau contribuent également à l’apport hydrique quotidien. L’essentiel est la régularité plutôt que la perfection.
Un contrôle simple consiste à observer la couleur des urines : un jaune pâle indique généralement une hydratation suffisante, tandis que des teintes plus foncées suggèrent un besoin accru de boire. Cette méthode pratique aide à limiter l’incertitude autour d’une habitude quotidienne pourtant fondamentale.
La bonne santé découle d’une accumulation de choix quotidiens, davantage que d’interventions spectaculaires. Même si une hydratation adéquate ne fera pas disparaître les pressions de la vie, elle pourrait aider votre corps à être mieux préparé pour y faire face. Dans un monde où le stress semble inévitable, cet avantage physiologique pourrait s’avérer plus précieux que nous ne l’avions jusqu’ici envisagé.
L’eau reste indispensable à la vie, bien au-delà de la simple survie. Nos travaux indiquent qu’elle pourrait aussi compter dans la gestion des exigences psychologiques de la vie moderne, en offrant un levier à la fois simple et puissant pour soutenir la résilience physique et mentale.
Daniel Kashi, chargé de recherche postdoctorale, Université Liverpool John Moores, et Neil Walsh, professeur de physiologie appliquée, Université Liverpool John Moores
Cet article est republié depuis La Conversation dans le cadre d’une licence « Communs créatifs ». Lire l’article d’origine.

Commentaires
Aucun commentaire pour le moment. Soyez le premier!
Laisser un commentaire